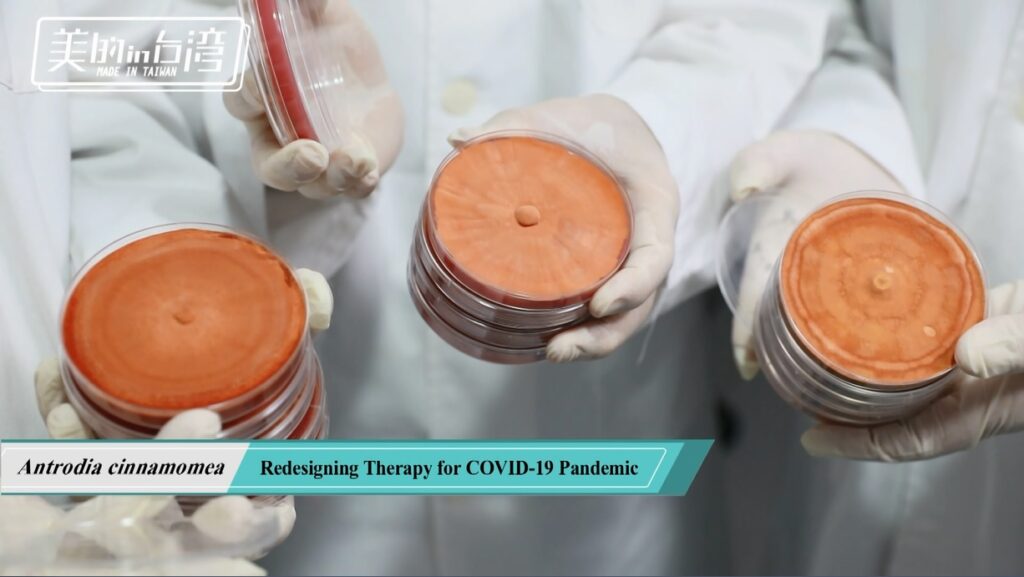
牛樟芝中草藥現代化&癌症精準健康 8 biomass phytochemical esg antrodia 皿培研究所 植化素 皿培 牛樟芝 子實體

牛樟芝(菇)的中草藥現代化研究以及在癌症精準健康的應用 高雄市抗癌服務協會-28週年紀念特刊 2022, P.22-25
吳永昌 教授簡介
◎高雄醫學大學醫學研究所(基礎醫學)博士
◎美國北卡羅萊納大學藥學院博士後研究
現任:
◎中國醫藥大學中西醫結合研究所講座教授兼附設醫院中醫藥研究發展中心顧問
◎台灣牛樟芝產業協會常務理事兼國家標準技術委員會召集人
◎經濟部標準檢驗局食品國家技術委員會委員
經歷:
◎高雄醫學大學天然藥物研究所講座教授
◎中國醫藥大學副校長
文/圖 吳永昌 博士/教授(本會理事)





40年的抗癌天然物及中草藥現代化研究分享
回顧40多年來在生技醫藥領域的研究歷程,前20年主要專注在台灣本土植物的天然物化學研究,釐清植物中對於人類健康具有療效的活性成分(植化素)。本實驗室對於番荔枝科植物(俗稱的釋迦)的種子、莖、葉各部位,長年進行其化學成分的分離純化、構造式鑑定。其中,發現番荔枝科乙醯生合成物(Annonaceous acetogenins)對於乳癌等婦科癌症具有顯著的抑制癌細胞生長活性,也成為本研究團隊的特色主題之一,累積超過400個acetogenins抗癌活性成分發表在國際醫藥學期刊,希望對於「癌症解方」的學術基礎研究能對這目前還是十大死因之首的疾病有所貢獻。自2003年開始政府國科會、中藥司、農委會等單位大力積極推動下,國內中草藥現代化研究蓬勃發展,希望中草藥能與西醫系統接軌、國際化,建立明確的活性成分、藥理機轉、食用劑量與服用方式,如德國的銀杏製劑。此時期本實驗室也榮獲國科會生技製藥國家型計畫補助,進行番荔枝科乙醯生合成物的抗癌「植物新藥WYC01」研發,同時在活性篩選超過百種台灣本土植物後,從粗毛金星蕨提取的新穎苯醌黃酮類(protoapigenone)也進行抗癌「小分子新成分新藥WYC02」的全合成及衍生物半合成研發。在進行本土植物的抗癌研究過程中,也於2005年開始針對台灣牛樟芝的活性成分進行天然物化學的學術研究以及中草藥現代化的相關產學合作。不同於WYC01、WYC02開發目標為西藥製劑的新藥漫長研發歷程,牛樟芝在民俗使用習慣上被認為是藥食同源的菇菌,能以食材、保健食品、健康食品的形式貼近民眾的生活。因此,在牛樟芝的抗癌研究道路上讓我們研發團隊更有「學術知識產業化」的成就感與使命感。下述的內容就針對自身參與的牛樟芝科研發展、以及在癌症精準健康的應用,以科普的方式與大家分享。
高貴不貴,牛樟芝一定要知道的3件事
一般民眾對於牛樟芝常見的第一個問題,就是牛樟芝的名字,是要叫「樟芝」、「牛樟芝」、還是「牛樟菇」?3種名稱指的是相同、或是不同的東西?牛樟芝為台灣特有的食藥用大型真菌,野生牛樟芝在全世界只被發現生長在台灣森林,且僅寄生於牛樟樹,顧名思義就是長在「牛樟」樹的真菌,那到底要稱為「芝」、還是「菇」呢,過去大家最習知具有療效的真菌就是靈「芝」,因此就自然而然通稱為牛樟「芝」;但根據形態與生育地,且「菇」較「芝」更接近台語發音,因此很多學者認為牛樟「菇」更恰當;而根據衛福部食藥署食品原料整合查詢平臺的規範,牛樟芝、牛樟菇皆指同一種素材、在名稱上都可使用且通用,樟芝則是口語上的簡稱。
牛樟芝為何被稱為「台灣森林的紅寶石」,是一般民眾第二個常聽到但沒法深入理解的議題,牛樟芝的外觀型態有3個特點,第1是:平伏貼生,上緣反捲形成菌蓋,漸長成半圓形、馬蹄形至不規則形,大小多變化;第2是:無菌柄,以寬闊的基部緊實生長在木材基質;第3是:新鮮菇體菌孔面呈澄紅色、血紅色至肉桂色,老化菇體則褪色為乳白至淡赭褐色。另外,稀有珍貴更是特色,野生牛樟芝生長極為緩慢,每年僅增長約新台幣壹拾元硬幣面積大小,鮮品菇體價格在每兩新台幣5,000-20,000元。由於牛樟芝外觀型態上的特點、加上取得的稀有珍貴,因此被稱為「台灣森林的紅寶石Ruby Mushroom in Taiwan Forest」。
第三個常見問題是牛樟芝「菌絲體」與「子實體」的比較,就生物形態學來說,菌絲體為營養構造、子實體為生殖構造,兩者並不相同,民俗療法中,採集的野生牛樟芝,即生長期較長的子實體。近十年來牛樟芝的人工栽培已從一開始的摸索開創期進入穩定生產的階段,原料及產品價格已可下降至野生牛樟芝的1/2-1/4。常見的人工栽培方法包括液態、固態、段木、皿培培養,都希望能達到和野生牛樟芝一樣的活性功效。近5年來更有突破性的發展,在學界業界的共同努力研究發展下,牛樟芝菌絲體、子實體的原料及產品研發都能達到中草藥現代化的水準與規格,建立明確的活性成分、藥理機轉、食用劑量與服用方式,多款牛樟芝產品皆取得健康食品-小綠人的護肝、免疫調節健字號認證,更有牛樟芝原料取得美國FDA的新膳食補充核准,而在生產時間及對應成本上,液態培養1-4星期能收成、固態培養1-3個月能收成、皿培培養4-9個月能收成、段木培養至少1年以上,對於消費者而言,就可依據自己的保健需求、產品標示、購買力,明智挑選適合的牛樟芝產品。
牛樟芝現代化科學化的發展進程
台灣民間(原住民)早期已將野生牛樟芝作為食用,相傳具有強肝解毒、治療腹痛、抗高血壓、抗癌等多樣性神奇功效,牛樟芝的現代化科學化發展,就是學界業界共同努力釐清、驗證牛樟芝活性成分、藥理機轉的研究歷程。1995年,牛樟芝特有的三萜類成分樟芝酸首次發表在天然物學術國際期刊,至今25年以上的持續研究,「臺灣博碩士論文知識加值系統」已收錄超過512筆的牛樟芝論文,「PubMed資料庫」2021年12月也累計556篇以上的國際期刊發表,牛樟芝可謂為台灣生技醫藥科學文獻發表篇數最多的天然藥物食品原料。
以適應症「活性確效」的研究演進來說,主要可分為4個時期,包括1.強肝解毒→2.抗癌防癌→3.三高慢性病→4.無好藥醫的病。最先開始是針對民間相傳牛樟芝能強肝解毒、解酒的功效,以動物實驗進行抗酒精肝纖維化、慢性酒精性肝損傷、脂肪肝等藥理作用探討。隨著牛樟芝開始廣為流傳,坊間也時不時能耳聞癌症病人吃牛樟芝病情得到控制的案例,因此全台灣學界、業界、法人研究單位皆此起彼落大量投入牛樟芝的抗癌防癌相關研究,主要包括乳癌、肺癌、肝癌、胰臟癌、大腸癌、血癌等。其中,由馬偕醫院團隊發現能抑制胰臟癌細胞生長的羊毛甾烷三萜類成分dehydrosulphurenic acid更被譽稱為馬偕一號(DSA)。近10年來,除了癌症領域外,牛樟芝的活性功效研究則導向三高慢性病的作用探討,麥角甾烷三萜類成分樟芝酸K能降低胰島素阻抗,樟芝酸的複合性作用顯示抗糖尿病、高血脂、預防肥胖、中風的功效。同時,近5年來隨著精準健康、亞健康調理的醫療模式興起,對於無好藥醫的疾病,牛樟芝被用於改善癌症惡病質、肌少症、類風濕性關節炎等活性研究,在新冠肺炎疫情期間,中研院、中興大學研究團隊發現牛樟芝有些三萜類成分能抑制ACE2(血管收縮素轉化酶2)蛋白活性以及本實驗室更証實有些三萜類成分尚能抑制SARS-CoV-2-Lentivirus particles pseudotyped (VPP)病毒之感染,進而對抗新冠肺炎病毒感染。
除了學界的努力外,政府對牛樟芝的法規以及產業的發展也越加完善。自2016年起,已規定:食品使用牛樟芝為原料時,需具備原料之詳細加工或製造過程、規格及90天餵食毒性試驗報告等相關證明文件,上市前必需送衛生福利部備查。對於牛樟芝產品外包裝更有明確規範,需標示原料使用部位為子實體或菌絲體及其培養方式,以及相關警語。CNS牛樟芝子實體的國家標準,經濟部標準檢驗局也在2010年開始啟動擬訂,歷經10年終於在2021年通過並於8月19日正式公告。制訂內容包含8大項目,其中,在指標成分含量測定上,更選定牛樟芝子實體的「8個三萜類活性成分」為指標成分,以高效液相層析法(HPLC)進行定性定量品質管控,檢驗規格遠高於台灣中藥典中藥材的2-4個指標成分。本人很榮幸能擔任台灣牛樟芝產業協會/國家標準技術委員會召集人、經濟部標準檢驗局/食品國家技術委員會委員,參與制訂貢獻所長。同時協助牛樟芝國際化之推動,使美國藥典-草藥綱要USP Herbal Medicine Compendium收錄牛樟芝為其品項,在產業發展上能與西方醫療系統接軌。
牛樟芝子實體在西醫系統、中醫系統的使用
目前台灣的健保制度係西醫、中醫並行的醫療體制,國民的就醫習慣也越來越喜歡各取西醫中醫之所長,西醫治標(急症)、中醫治本(調理),也因此醫院開設的「中西醫結合科」越來越受青睞。雖然西醫系統、中醫系統在診斷、治療、用藥方式上都有所不同,但皆著重如何改善發炎所引起的疾病、以及疾病所引起的發炎,尤其是身體的「慢性發炎」。而牛樟芝在20多年來現代化科學化的發展下,已建立明確的活性成分、藥理機轉,以子實體的三萜類成分樟芝酸A、B、C、K、H為例,其多樣性功效,源自能「同時」抗氧化、抗發炎,能增加抗氧化酵素活性,包括過氧化氫酶(catalase)、超氧化物歧化酶(superoxide dismutase)、穀胱甘肽過氧化物酶(glutathione peroxidase),有利於肝臟細胞排除自由基,增加肝臟過氧化氫酶(catalase)與乙醛脫氫酶(aldehyde dehydrogenase, ALDH)活性,也能抑制促發炎因子(inflammatory cytokine、proinflammatory cytokine)表現,包括腫瘤壞死因子(tumor necrosis factor, TNF)、白介素-1β (interleukin-1β, IL-1β),降低發炎相關細胞激素,加上近年來推動的中藥材原料、保健食品原料台灣本地自產化,歷經20年中草藥現代化洗禮的牛樟芝,相當適合西醫系統、中醫系統、中西醫結合上的使用。
牛樟芝子實體在癌症的食用輔助以及未來發展
每一抗癌新藥從探索發現到成功上市,歷經基礎研發、臨床前試驗、人體臨床一期至四期試驗,平均需要花費10-15年、10-12億美金。因此,雖然牛樟芝已有百篇以上的癌症相關研究文獻報導,但真的要能取得新藥藥證,仍有漫漫長路需要人力、物力、資金上的支持與突破。然而,牛樟芝的抗癌研究也持續往人體臨床試驗前進,2019年國立東華大學研究團隊發表了牛樟芝子實體對於乳腺癌、小細胞肺癌患者的治療效果。雖然目前癌症仍是台灣十大死因之首,但由於醫療水平的進步,民眾已不再像早年的聞癌色變、驚慌失措、聽信偏方,都能盡快接受正規治療,更有多元管道能獲得術後的調理保養照護。牛樟芝在「癌症精準健康」上輔助治療、預防復發的功效作用,根據近10年來的田野調查,也確實有觀察到牛樟芝子實體能降低化療、電療產生的精神不振、食慾不佳副作用,癌症療程後服用牛樟芝子實體,大多反應能有預防癌症復發的作用,未來下個10年,實需繼續仰賴產官學的眾志成城,在目前累積20年所建立的牛樟芝中草藥現代化研究基石上,更進一步的釐清與驗證之。

吳永昌博士/教授,接受美的in Taiwan節目國際版英文專訪,以「牛樟芝-疫情時代新保健」為題進行分享

吳永昌博士/教授,擔任台灣牛樟芝產業協會/國家標準技術委員會召集人、經濟部標準檢驗局/食品國家技術委員會委員,推動CNS牛樟芝子實體國家標準的制訂;擔任美國藥典委員會東亞專家代表協助USP Herbal Medicine Compendium納入牛樟芝為其品項
牛樟芝的中草藥現代化人工皿培生產
牛樟芝的科學化與現代化 牛樟芝(菇)的中草藥現代化研究以及在癌症精準健康的應用 高雄市抗癌服務協會-28週年紀念特刊 2022, P.22-25